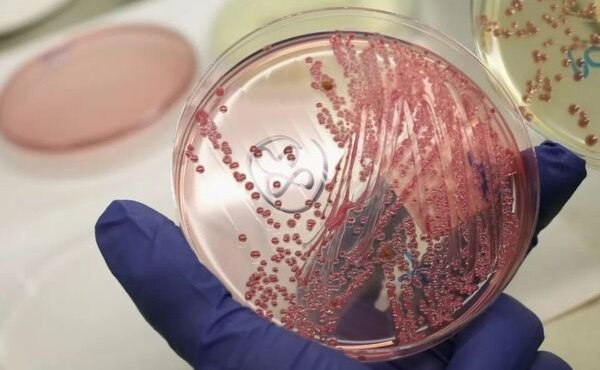

- Маєте запитання?
- (0332) 780293
- vpravda@gmail.com
В Україні виявили сибірську виразку
На Одещині підтвердили випадок захворювання на сибірську виразку – інфекційну хворобу, що вражає людей і тварин. Сибірку виявили в мешканця села Фараонівка Саратського району. Про це повідомляє прессцентр ДСНС України.
“13 серпня лабораторно підтверджено захворювання на сибірську виразку у мешканця села Фараонівка, який перебуває в інфекційному відділенні Саратської центральної райлікарні. В осередку захворювання проводиться комплекс санітарно-гігієнічних та протиепідемічних заходів”, – сказано в повідомленні.
Хворий займався перекупом свійських тварин і відчув себе зле на початку серпня, однак зволікав зі зверненням до лікаря.

Більше читайте новин на нашому телеграм каналі та на сторінці у Facebook